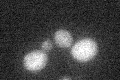
YLR410W
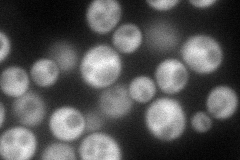
YLR410W
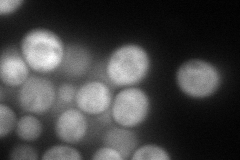
YLR410W
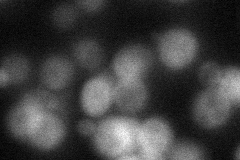
YLR410W

View description
Inositol hexakisphosphate (IP6) and inositol heptakisphosphate (IP7) kinase; generation of IP7 by Vip1p is important for phosphate signaling; likely involved in cortical actin cytoskeleton function, by analogy with S. pombe ortholog asp1
Localization:
Intensity:
Fold change:
Significance:
-
C’ GFP library in SD
below threshold15.95 -
N' NOP1pr-GFP in SD
cytosol113.755 -
N' TEF2pr-mCherry in SD
cytosol116.689 -
N' NATIVEpr-GFP in SD
cytosol34.7268 -
N' TEF2pr-VC and Cyto-VN in SD

#N/A0 -
C’ GFP library in SD+DTT

cytosol16.881.05No -
C’ GFP library in SD+H2O2

cytosol19.031.19No -
C’ GFP library in Starvation Media

cytosol15.120.94No -
C’ GFP library on the background of Pup2-DaMP

below threshold -
C’ GFP library on the background of CCT mutant

below threshold18.86651.18271No
